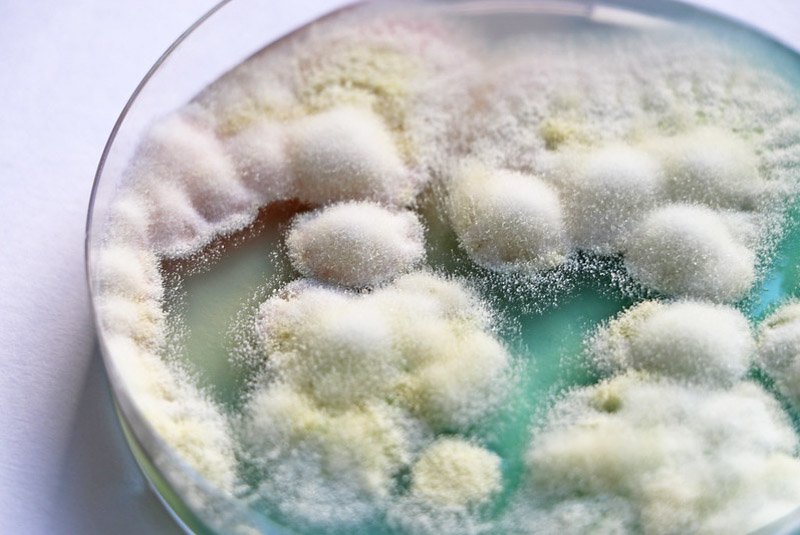

Этика в биоарте: когда искусство становится безумием?
В 1996 году художника под псевдонимом Стеларк посетила идея вырастить на себе третье ухо, которое будет неким звуковым порталом для людей со всего мира, давая им возможность проживать совместный аудиальный экспириенс с автором посредством Wi-Fi. Через 11 лет первый этап был выполнен — Стеларк, используя биоматериалы, встречающиеся в работе пластических хирургов, поместил «ухо» под кожу левой руки.

Стеларк «Третье ухо»
Каркас прижился к организму художника и сейчас Стеларк воспринимает «ухо» как естественную часть себя. Однако, реакция общества была противоречивой: некоторые считали Стеларка гением, другие же с презрением восприняли работу как нечто отталкивающее. Тем не менее, именно «Третье ухо» по сей день является одним из самых ярких произведений биоарта.
Биоарт — это направление современного искусства, в котором инструментами художника становятся бактерии, живые организмы и ткани, жизненные процессы и всё то, что мы можем представить под словом «био».

Эдуардо Кац «Капсула времени»
Термин «биоарт» был впервые упомянут в 1997 году Эдуардо Кацом при определении жанра своей перфоманс-инсталляции «Капсула времени». В свою ногу художник вшил чип, к которому зрители могли подключаться дистанционно. Данные, хранящиеся в нем, несли информацию и фото из жизни Каца. Так аудитория будто проникала в воспоминания артиста.
Эдуардо Кац — Трансгенный цветок с ДНК художника
Несмотря на то, что именно Кац дал название новому направлению в искусстве, считается, что первым биохудожником был Александр Флеминг. Ученый не только сделал значимое медицинское открытие пенициллина, но нашел его применение в искусстве. Экспериментируя с бактериями в чашке Петри, Флеминг создавал первые картины в жанре биоарт.


Картины Александра Флеминга в чашке Петри
Метод рисования бактериями широко используется и по сей день.
Совершенствование научных технологий повлияло на развитие биоарта. Синтез инновационных решений и биологических материалов создает предметы искусства на стыке «живого» и «неживого».
Дарко Вукич «Гальванизация ребенка». Размышления на возможность будущего покрывать неродившегося ребенка серебром и сохранять в качестве предмета искусства.
«Я создала живых бабочек, узоры крыльев которых были изменены в художественных целях. Такие изменения были достигнуты путем вмешательства на стадии развития крыла, что привело к формированию нового рисунка, никогда ранее не встречавшегося в природе. Крылья бабочки состоят исключительно из нормальных клеток, без искусственных пигментов и рубцов, но созданы художником. Эти крылья — пример чего-то одновременно естественного, но возникшего в результате вмешательства человека. Художественное вмешательство оставляет гены бабочки неизмененными. Таким образом, новые закономерности не передаются потомству модифицированных бабочек. Новые узоры — это то, чего никогда раньше не существовало в природе, и что быстро исчезает из природы — их больше нельзя увидеть. Эти произведения искусства буквально живут и умирают. Они являются образцом искусства с продолжительностью жизни — продолжительностью жизни бабочки. Они являются примером чего-то, что одновременно является искусством и жизнью», — Марта Де Менезес
Марта Де Менезес — «Природа?»
Однако, если результат биоарта понятен — создание содержательных предметов искусства, то разгадать цели художников немного сложнее. Осмыслить место человека во Вселенной, осветить проблему экологии, способствовать популяризации биотехнологии… Что, если именно отсутствие какой-то одной общей цели между деятелями создает резонанс в реакции общества на произведения? Актуальным стоит вопрос этики биоискусства: допустимо ли использование живых организмов, даже если речь идет о простом наборе клеток, для выражения своего манифеста?
Йоко Шимицу «Биодинамики»
Джо Девис «Бактериальное радио»
Алана Линч «Интуитивное чувство» («Gut feeling»)
Мириам Симун «Звук шмеля, отказывающегося колонизировать искусственное гнездо»
С одной стороны, нельзя отрицать, что искусство в целом является рычагом развития философской мысли. Такой же принцип относится к биоарту. Произведения поднимают острые темы и привлекают внимание общества к ним.
Анна Лаура Кантера «Менструальные нити»
«Сейчас я вяжу и развязываю свое тело. Я использую свою менструальную кровь, чтобы разобрать и раскрыть себя в образе женщины, со всем, что с этим связано. В процессе плетения я отказываюсь от своей истории и вяжу новую», — Анна Лаура Кантера
Анна Димитру «Сифилис платье»
Осбанова София «Я Другой»


Шпела Петрич «Противостояние растительной непохожести»
Кроме того, биоарт освещает открытия в научном мире. Что плохо в популяризации открытий пластичекой хирургии, генной и клеточной инженерии, клонирования объектов?
Эми Карле «Регенеративный реликварий»
Нил Харбисон — Антенна, передающая цвета звуковыми волнами
Йоко Шимицу «Соноситез»
Дарья Леконцева «Я вас слышу: паросмия и другие призраки COVID-19»,
Противники биоарта считают, что художники заходят слишком далеко в попытках создать «киборг-человека», нарушая природные законы. В качестве аргумента приводится отсутствие доказательной базы безопасности чрезмерных вмешательств в свой организм. Так, например, художница Мун Рибас в попытках расширить спектр своих ощущений вшила в свои ноги и руки сейсмические индикаторы, которые вибрировали каждый раз при землетрясении в любой части планеты. После семи лет эксперимента, художница удалила импланты, не объясняя причины, однако, призналась, что теперь чувствует фантомные вибрации в своем теле и с трудом привыкает к «обычной» жизни.
Мун Рибас танцует, слушая вибрации сенсоров
Орон Кэттс и Ионат Зурр «Несодранная кожа»
Хезер Дьюи Хаборг «Наверное Челси». Каждое лицо смоделировано посредством изучения ДНК незнакомцев
Методы биоискусства иногда включают использование животных как инструментов. Защитники зоомира уверены, что нет необходимости в том, чтобы пресекать границы живых существ.
Эдуардо Кац «Проект Альбо». В гены животных вливались ген медузы для получения флуоресцентного эффекта


Брендон Баланжере « Новые реликварии Малампа»
Марион Лаваль-Жанте и Бенуа Манжен «Пусть лошадь живет во мне!»
И если биоарт пытается выйти за границы существующего в природе, как тогда определить в какой момент искусство становится безумием?
Марта Де Менезес «Анти-Марта»
Роза Каннибал «Гемоглофилия (Рецепты как удалить голод каннибала)»
Орлан «Возрождение Святой Орлан»
Пекка и Тейя Исораттьяс «Робот-инвалид»
Несмотря на резонанс реакции общества, биоарт продолжает существовать и развиваться. Каждое произведение биоискусства напоминает нам об изменениях в технологиях и всеобщей новой волне модернизации. Возможно, именно это ощущение чего-то неизведанного и чего-то, что «сильнее» природы вызывает у некоторых зрителей чувство страха, пока другие восхищаются способностям человека конструировать мир. Так этично ли биоискусство?


Гопка Виктория, Каплан Ася, Осбанова София «Живой труд»
Используемые источники